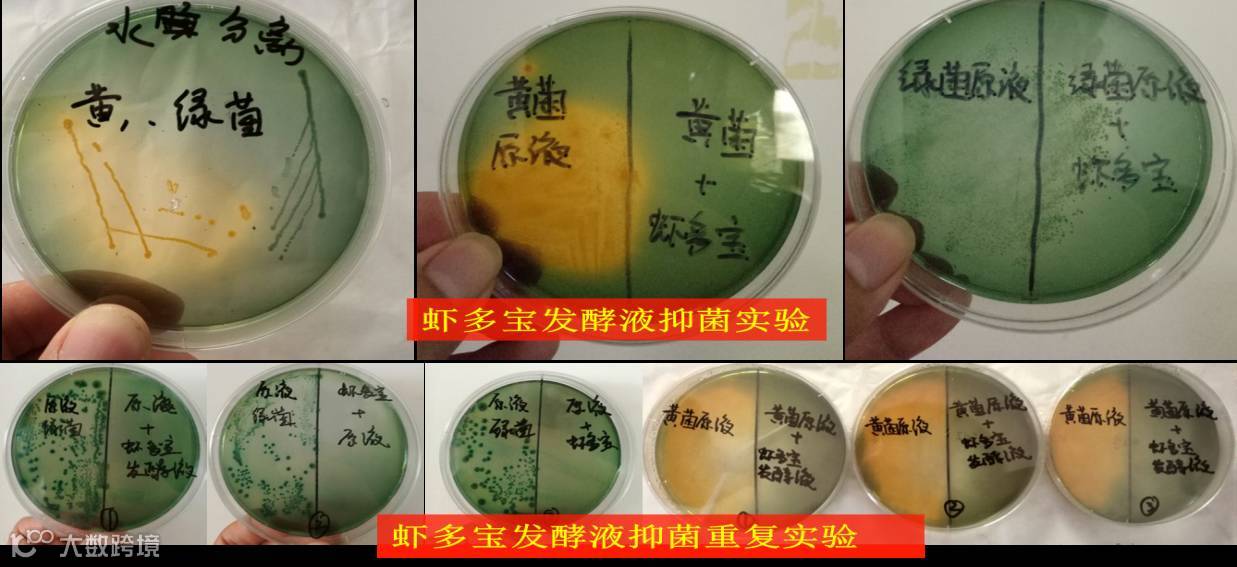

文 | 图 福建海大 王福扬、李佳凯
形式逼人
国外对虾大量涌入中国
随着全国对虾养殖环境的不断恶化,全国对虾产业已经从2013年的140万吨下降到2016年的70万吨,中国已经从虾类净出口国变成了依赖进口为主的国家;于此同时,泰国、越南、印度度过2013、2014、2015年的不稳定期,到了2016年随着模式的调整和政府的干预,总产量都有明显的上升,尤其是越南,虾类销量30%左右出口到中国,中国已经成为越南最大对虾出口国。

淡季上市活虾
能有效避开进口冻虾竞争

继续依赖露天塘养虾,依赖低成本集中上市,依赖出口冻虾来减轻集中上市带来的市场压力,在现在这样的养殖形式下,将会越来越难。如何避开集中上市,如何实现淡季上市鲜活大虾对于我们来说至关重要。
根据福州和全国各地的水温情况,如果实现用小棚标粗,低密度大塘快速养成,是一种可以实现较高盈利养殖方式。
快速养成模式
小棚标粗,低密度大塘养成
小棚标粗效益分析

通过效益分析我们可以看出,在两造虾盈利,单造产量只有400斤的情况下,亩盈利依然能够达到10000元,而周边单造盈利低于5000元。如果我们继续提高成功率,或者在单造比较好的情况下,继续坚持养大虾,那么盈利水平可能会更上一层楼。
小棚标粗放苗时间的选择
以闽东区域为例,外塘水温一般在4月20日以后才能达到20℃以上。
标苗时间选择

首次放苗时间:可以选择在3月20日左右,首次标苗的时间一般需要一个月左右。在4月20日分苗后,经过适当准备,可以进行第二次标苗;
第二次标苗时间:可以选择在5月10日左右,随着气温的增加,标苗时间不断减少,标苗20天左右就可以分苗,第二次分苗时间可以选择在5月30日左右(这时候第一批大虾已经到了50条左右每斤);
第三次标苗时间:选择在6月25日左右,标苗15天,7月10日分苗,
第四次标苗时间:选择在8月5日,8月15日分苗;(气温不断升高,标苗时间不断减少)。
在这样的规划前提下,每批苗在生长了50天以后才有下一批苗下塘,只要密度合理,下一批虾就能快速养成。
小棚标粗的方式


1、放养密度设计
小棚标粗密度:由于标粗期间要保证对虾的快速生长和1个月的养殖周期,小棚标粗的密度不能太高,如海大福清基地选择的500尾/平方,就能保证对虾在小棚内养殖一个月有比较好的生长速度和生长安全。
大塘养成密度:由于每批虾都有50天以上的独立生长时间,低密度快速养成至关重要,建议每亩放苗量不高于2万尾/亩,这样既能降低养殖风险,又能快速生长。
2、小棚标粗苗种选择
由于小棚标粗需要实现快速养成,苗种的选择至关重要,一般建议选择大厂家的一代苗,如海兴农一代苗,独有的三大二叉一长身特征(三大:头大、眼大、肠胃大;二叉:尾扇和眼柄叉开幅度大;一长身:身体修长),有优质的虾苗,让你的养殖赢在起跑线。
3、小棚标粗饲料选择
小棚标粗大塘养成比拼的就是速度。要实现60天长到40条左右,在饲料选择方面一定要选择档次比较高的饲料,如福建海大虾康宝(容川虾大大),独有的配方,让你在同样的养殖周期中,虾更肥、更壮、更快上市!
小棚标粗关键技术点
地下水提前消毒、曝气、解毒:在养殖密集区域,外河水受到污染越来越严重,地下水养虾是非常好的选择!但大部分地下水中会有重金属,氨氮等,所以建议提前进水和处理水。地下水含有重金属区域可以提前10天左右进水,进水后第二天可以使用漂白粉消毒,氧化大部分重金属,第三、第四天消毒后的水不再红和黑时,可以使用10PPM的EDTA和2PPM的海联科201解除重金属影响等,进水后24小时不停曝气也是降低重金属和氨氮的一个重要手段。
菌藻平衡很重要
为什么要努力保持平衡
从pH稳定方面考虑:藻类光合作用消耗大量二氧化碳,使池塘的pH不断升高;大量的活菌生长其代谢产物大部分为酸性,部分活菌生长过程中也会产生二氧化碳,使池塘pH不断下降,只有菌藻平衡pH才会稳定,水质指标才会相对稳定,才能调出对虾养殖需要的PH值7.8—8.6。
从控制氨氮和亚硝酸盐角度考虑:藻类生长需要利用氨根离子和硝酸盐,这时候的氨氮、亚硝酸盐就会不断转换成氨根离子和硝酸盐;间接使氨氮、亚硝酸盐不断下降;而菌体蛋白主要由碳、氢、氧、氮组成,活菌的快速生长也将快速消耗池塘中的氨氮和亚硝酸盐。
从生物链角度考虑:如果没有活菌参与,藻类大量繁殖也会出现大量死亡的现象。藻类生长需要光合作用;即使我们补充充足的营养,藻类也会因为上层藻类大量繁殖而阻挡了下层藻类的阳光,出现下层藻类大量死亡的现象(这就是我们平时养殖过程中出现的过肥的水一般都有死藻的现象);只有大量的菌类繁殖起来,和藻类竞争营养,才能让藻类不至于过度繁殖。
从总菌抑制弧菌角度考虑:通过大量实验验证,有害弧菌的大量繁殖都是因为池塘中总菌数量不够多,而总菌数量不够多的原因又是因为菌种的单一或者环境的不适宜,所以池塘中培养大量有益菌是提高总菌的有效手段,只有总菌和有益菌足够大,才能有效抑制弧菌!
“海大二泡全家桶”
最划算、最全面、最简单的实现菌藻平衡方式
“一泡泡菌”:单斤使用成本才0.65元,在正确发酵方式下,每毫升总菌数达到0.5*109,在抑制弧菌方面,也得到非常好的验证, 有效控制有害菌。
“二泡泡肥”:补肥的同时,考虑到氮、磷、钾、钙、镁、碳,等元素,非常适合藻类生长,真正实现了菌藻平衡。


